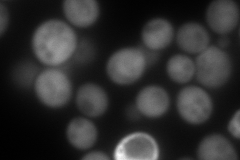
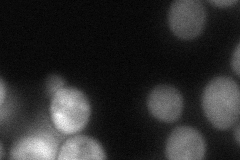
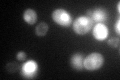

View description
Peptidyl-prolyl cis-trans isomerase (cyclophilin), catalyzes the cis-trans isomerization of peptide bonds N-terminal to proline residues; binds to Hsp82p and contributes to chaperone activity
Localization:
Intensity:
Fold change:
Significance:
-
C’ GFP library in SD

cytosol108.41 -
N' NOP1pr-GFP in SD

cytosol298.539 -
N' TEF2pr-mCherry in SD
cytosol362.382 -
N' NATIVEpr-GFP in SD

cytosol139.479 -
N' TEF2pr-VC and Cyto-VN in SD
cytosol76.592 -
C’ GFP library in SD+DTT

cytosol163.511.5Yes -
C’ GFP library in SD+H2O2

cytosol146.941.35No -
C’ GFP library in Starvation Media
nucleusN/AN/AYes -
C’ GFP library on the background of Pup2-DaMP

cytosol -
C’ GFP library on the background of CCT mutant

cytosol114.4751.05594No
